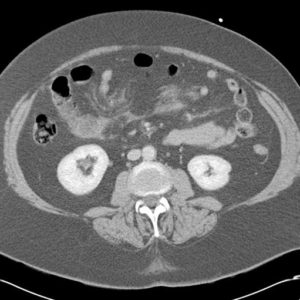
Chấn thương mạc treo

TIÊU HOÁ
Hiển thị 941–960 của 1445 kết quảĐã sắp xếp theo mới nhất
-

Ung thư đường mật
Lượt xem: 184» 10-05-2019 -

U ruột non
Lượt xem: 207» 10-05-2019 -

U ruột non
Lượt xem: 235» 10-05-2019 -

U ruột non
Lượt xem: 172» 10-05-2019 -

Hội chứng Fitz hugh curtis
Lượt xem: 671» 07-05-2019 -

Hội chứng Fitz hugh curtis
Lượt xem: 208» 07-05-2019 -

Khí tĩnh mạch cửa
Lượt xem: 194» 06-05-2019 -

Viêm ruột thừa
Lượt xem: 256» 05-05-2019 -

Viêm ruột thừa
Lượt xem: 185» 05-05-2019 -

Viêm ruột thừa
Lượt xem: 198» 05-05-2019 -

Túi thừa thực quản
Lượt xem: 160» 03-05-2019 -

Chấn thương mạc treo
Lượt xem: 114» 28-04-2019 -

Chấn thương mạc treo
Lượt xem: 156» 28-04-2019 -

Chấn thương đại tràng
Lượt xem: 155» 27-04-2019 -

Chấn thương đại tràng
Lượt xem: 143» 27-04-2019 -

Chấn thương mạc treo
Lượt xem: 189» 27-04-2019 -

Chấn thương ruột non
Lượt xem: 180» 27-04-2019 -

Chấn thương đại tràng
Lượt xem: 235» 27-04-2019 -

Chấn thương mạc treo
Lượt xem: 203» 27-04-2019 -

Co thắt tâm vị
Lượt xem: 156» 26-04-2019